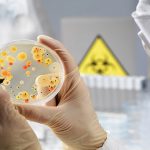
Transgenic fruit flies help scientists trace the cascade of symptoms caused by toxic infection — Tdnews Transgenic fruit flies help scientists trace the cascade of symptoms caused by toxic infection -- Tdnews

Report: Bioengineers 3D-print implants to seed multiple layers of tissue
Who ever said bioengineers can't get their groove on? The Rice University team led by Antonios Mikos says otherwise with its development of a...
Researchers discover how rogue communications between cells lead to Leukaemia
New research has deciphered how rogue communications in blood stem cells can cause Leukaemia.
The discovery could pave the way for new, targeted medical treatments...
Norovirus outbreak in Louisiana casino leaves 200 ill, Report
Louisiana state health officials are investigating a norovirus outbreak.
Health officials are responding to an outbreak of norovirus at a Lake Charles casino after people...
Report: Antioxidant reverses BPD-induced fertility damage in worms
From plastics to pesticides, it seems like every week delivers fresh news about the dangers of endocrine disruptors -- chemicals in the environment that...
Report: Few consumers understand THC levels in cannabis edibles
Few cannabis consumers understand what the THC numbers on packages of cannabis edibles really mean, according to a new University of Waterloo study.
The study,...
New study shows how indole can reduce inflammation, fatty deposits
A new study led by Texas A&M AgriLife Research scientists shows how a natural compound found in many well-known and widely consumed vegetables can...
Transgenic fruit flies help scientists trace the cascade of symptoms caused by toxic infection...
The Clostridium difficile pathogen takes its name from the French word for "difficult." A bacterium that is known to cause symptoms ranging from diarrhea...
New gene therapy method improves vision in mice with congenital blindness — Tdnews
Mice born blind have shown significant improvement in vision after undergoing a new gene therapy developed by a team of Japanese scientists.
The results were...
Report: Is it possible to reduce political polarization?
In the run-up to the 2016 U.S. presidential election, an unusual experiment suggested that it might be possible to influence American voters to adopt...
Report: Chemical found in drinking water linked to tooth decay in children — Tdnews
Children with higher concentrations of a certain chemical in their blood are more likely to get cavities, according to a new study by West...
Top News
Hey ISIS, You Suck: Local Muslims Post Anti-ISIS Billboard
A new billboard on Manchester Road in Missouri reads, "HEY ISIS, YOU SUCK!!! From: #ActualMuslims."
A group of Muslim-Americans have put up a blunt billboard...